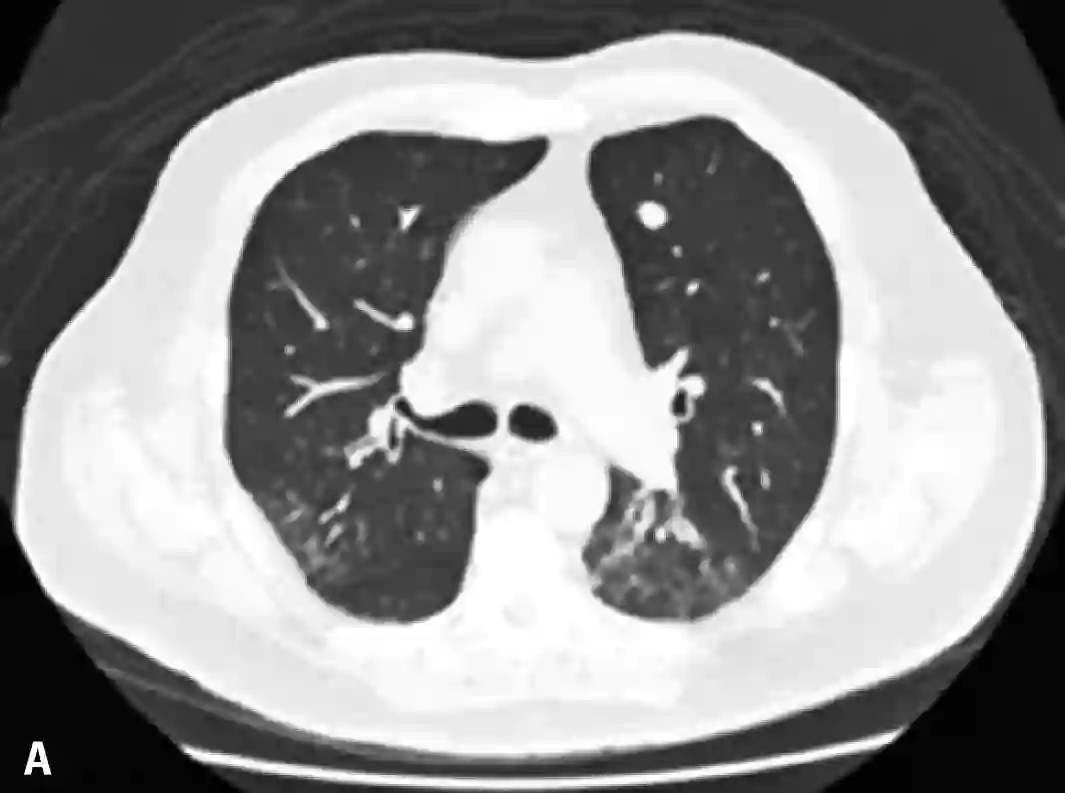

【1786】担心免疫治疗副作用?“早”字是关键!
对于那些晚期癌症病人来说,免疫治疗的优越性毋庸置疑,多种免疫治疗药物的突破和发展正使得癌症逐步成为一种慢性疾病,但是,任何药物都有副作用,免疫治疗药物,特别是PD-1/PD-L1抑制剂带来的免疫相关不良反应也一直是免疫治疗应用推广之路上的一项阻碍。近日,Henrique Alkalay Helber等人报道了5名因免疫治疗而发生免疫相关性肺炎的病例,此类针对具体病人的报道相信会给今后的治疗和预后评估提供新的依据。
病例一
患者是一名69岁的老年男性,身患晚期转移性结肠癌,肿瘤已经转移到了肝、肺和骨组织。患者曾接受了氟嘧啶、铂、抗血管生成药、伊立替康和西妥昔单抗,但是不幸的是,所有治疗最终都没能改变病人的情况,肿瘤病情一直在持续不断的恶化,考虑到病人的实际情况,患者开始接受帕博利珠单抗(Pembrolizumabe)的治疗,每两周10mg/Kg,在第二次治疗之后,病人开始出现了发热和呼吸困难。体格检查显示,病人的血氧饱和度仅为83%,CT检查显示其左肺出现间质性肺炎,双侧胸腔都存在积液,血细胞计数显示病人的白细胞增多。为了控制肺部症状,患者在行胸腔穿刺术后,又使用了头孢曲松+克拉霉素,但是病情却并没有出现好转。CT复查显示病人的病情并没有因抗生素的使用而出现好转,反而进一步加重,双肺磨玻璃影进一步扩大。
病例二
患者是一名73岁的老年男性,左大腿存在黑色素瘤病灶。病人在发病早期就接受了局部切除治疗,并在日后的过程中坚持随访。直到术后第8年,病人检查出了肺部的黑色素瘤转移病灶,其开始使用达卡巴嗪和伊匹木单抗进行治疗,但是病情的进展过程并没有被抑制,因此,病人开始使用帕博利珠单抗每3周2mg/kg的方案进行治疗。但是在第一次治疗后的14天时,病人开始出现干咳(无其他症状),CT检查显示其双侧肺部都出现了磨玻璃样改变。病人被确诊为帕博利珠单抗导致的肺炎,并迅速接受了1mg/kg强的松联合抗生素的治疗,万幸的是病人的肺部症状在用药治疗后出现 了明显的好转。2个月后,病人的肺部炎症反应被完全治愈,并对持续进行的帕博利珠单抗治疗表现出了良好的耐受性。
病例三
患者是一名81岁的老年男性,身患ⅢA期难治性肺腺癌。病人在进行手术治疗后又接受了放疗和卡铂+培美曲塞的辅助化疗。在随访4个月后,病人的病情出现了局部复发,在放疗治疗无效后,病人又接受了卡铂和紫杉醇的姑息性化疗,但是其病情并未得到有效的控制。同样,病人在传统治疗无效后选择了帕博利珠单抗每3周2mg/kg的免疫治疗方案。在治疗4个疗程后,病人开始出现呼吸困难和干咳,血氧饱和度也降至80%。CT检查显示双侧肺部出现弥漫性浸润灶,血常规检查显示其白细胞计数增高。所幸的是,病人在对症使用甲基强的松龙2mg/kg和抗生素治疗后,其肺部炎症得到了比较好的控制。
病例四
患者是一名54岁的老年男性,被确诊为肺大细胞神经内分泌癌,并且已经出现了转移。最初,病人使用了卡铂和紫杉醇进行治疗,随后又使用了顺铂和依托泊苷,同时接受了定向放疗。但是传统治疗的疗效并不理想,病人很快出现了中枢神经系统和肝脏的转移,因此帕博利珠单抗每3周2mg/kg的治疗方案再次临危上阵。在治疗5个疗程后,病人开始出现呼吸困难和咳嗽(无发热),氧饱和度仅为84%,CT检查显示其双肺出现了磨玻璃样变性。因此,病人开始每6小时使用哌拉西林-他唑巴坦4.5g的甲羟泼尼松2mg/kg进行治疗,在治疗开始后的24小时内,病人的肺部病情就出现了好转,治疗1周后的CT检查显示,病人肺部原先的浑浊阴影几乎全部消失。
病例五
该患者是一名70岁的老年男性,患有转移性肺表皮样癌合并多发性肝损伤。因患者的基本状态并不适用于铂类化疗,因此病人直接使用了纳武利尤单抗(Nivolumab)每2周3mg/kg进行治疗。在治疗4个疗程后,病人开始出现精神混乱、呼吸困难和干咳等症状(无发热),其血氧饱和度也跌到了74%,血细胞计数正常。CT检查显示其肺部出现了磨玻璃样浸润区。因考虑患者可能出现了免疫相关性的肺炎,其开始接受甲基强的松龙每8小时60mg的治疗,抗生素治疗也同步进行。仅仅在数小时内,患者的病情就出现了好转,并在治疗3天后就完全治愈出院。
在本次报道的5名病人中,仅有一人为5级不良反应,并最终去世。其他4名病人均为3级不良反应,在接受糖皮质激素治疗后病情都有改善。大多数病人的CT表现肺部的磨玻璃样改变,早期临床表现为咳嗽和呼吸困难,不论对于病人还是医务工作者来说,免疫性肺炎的早诊断和早治疗都尤为重要,以上报道的病人中,有几人就是因为早诊断早治疗,在很短的时间内肺炎症状就得到了快速的缓解,因此我们说:肺炎不可怕,“早”字是关键。
1. Helber, H.A., et al., Immunotherapy-induced pneumonitis: cases report. Einstein (Sao Paulo), 2018. 16(2): p. eRC4030.
28个肿瘤相关临床试验招募患者
点击下方图片即可查看详情